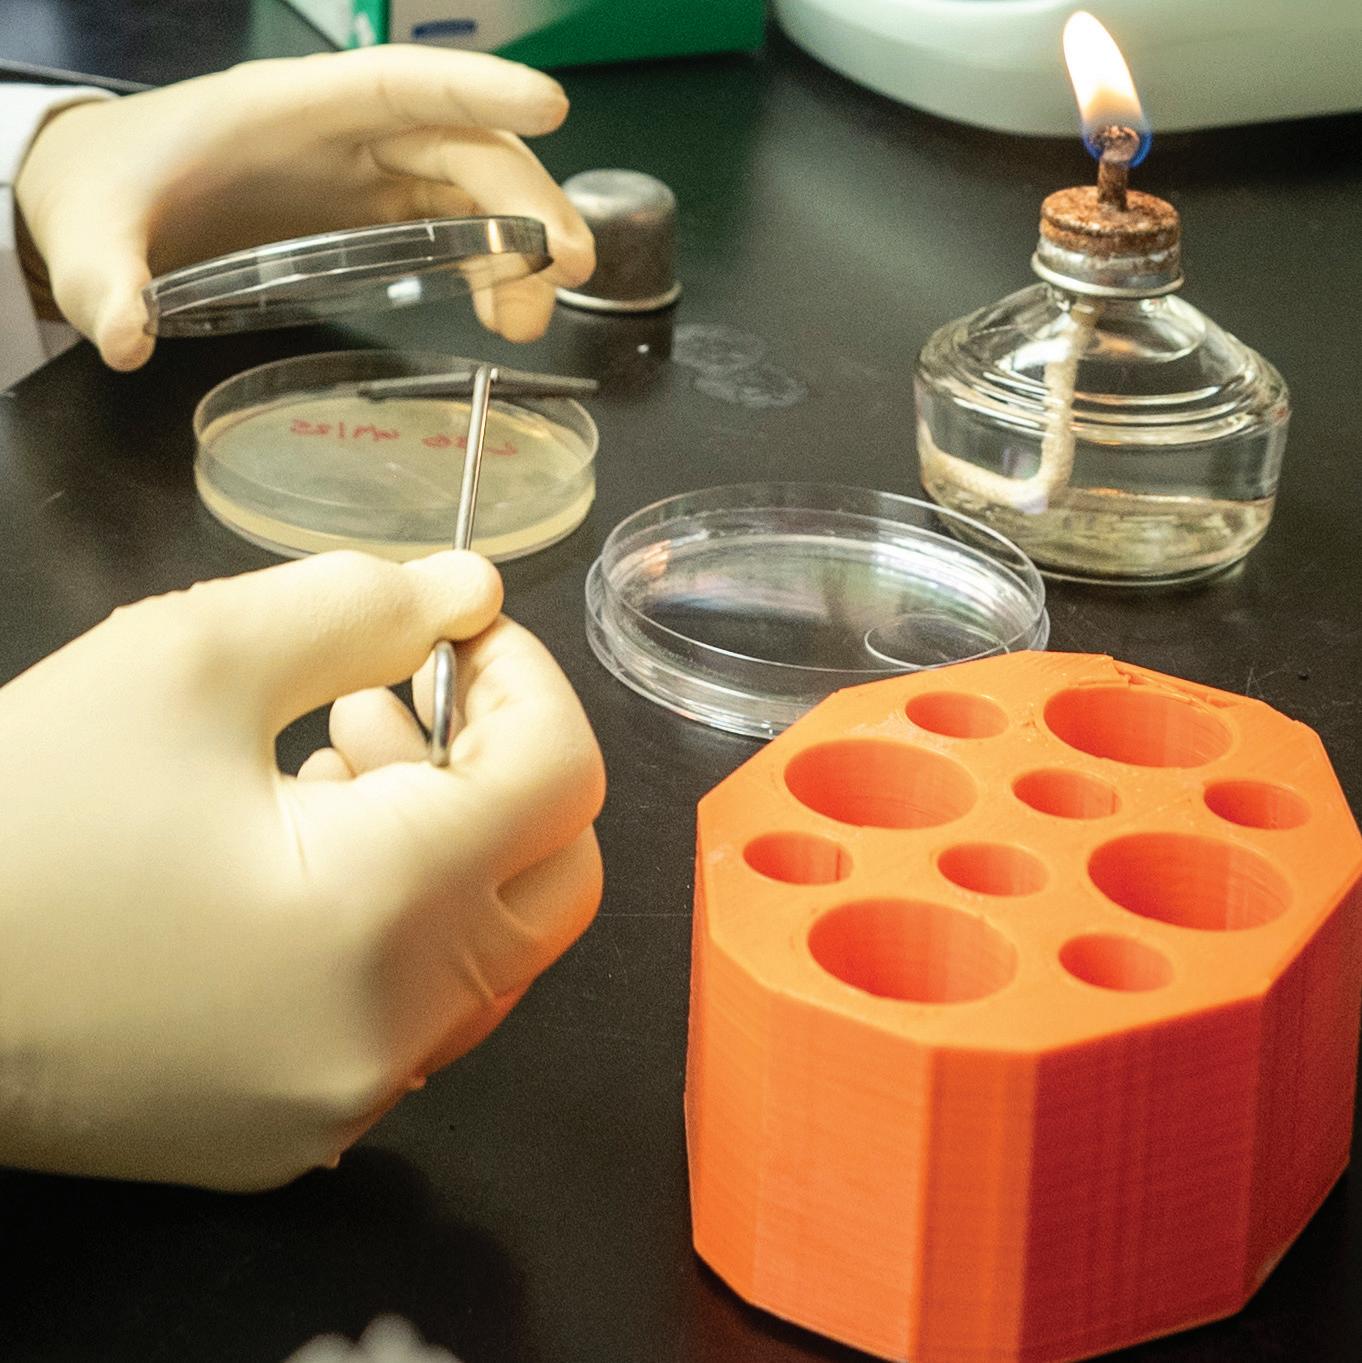

![]()













This Charlie 1 Horse felt hat, Carolina Herreradesigned jumpsuit, and Haybelle Co. statement necklace were worn by Lainey Wilson on the red carpet at the 2023 CMA Awards.
From the exhibit Lainey Wilson: Tough as Nails
artifact: Courtesy of Lainey Wilson artifact photo: Bob Delevante


RESERVE TODAY

















Development Threatens to Choke Out Wedgewood-Houston’s Creative Class
AJ Capital has turned the area into a construction site. Will a neighborhood emerge? BY ELI
MOTYCKA
The State of School Safety
As MNPS heightens safety measures, student concerns persist BY JULIANNE
AKERS
Hey, Thanks
Our thank-you notes to the community advocates, health care workers and others who make Nashville special BY SCENE STAFF AND CONTRIBUTORS
Grand Ole Opry 100th Anniversary Shows, Maisy Owen, The Big Lebowski, William Tyler & Friends and more
Many Visions of Liberation
Be Gay, Do Crime is a daily history of queer resistance and resilience BY MARIA BROWNING; CHAPTER16.ORG ART
Underneath It All
An exhibition of art by Fahamu Pecou explores identity and humanity BY JULIANNE AKERS

Vinyl Destinations
Your quick-reference guide to Record Store Day Black Friday 2025 in Nashville BY HANNAH CRON
Come Up to the Lab
Thomas Dolby remains a singular force in pop music BY JASON SHAWHAN
FILM
My Thoughts Remain Below Career-best performances from Jessie Buckley and Paul Mescal elevate Chloe Zhao’s Hamnet BY D. PATRICK RODGERS NEW YORK TIMES CROSSWORD AND THIS MODERN WORLD MARKETPLACE ON THE COVER: Illustration by Taylor Stringer
SUBSCRIBE
NEWSLETTER: nashvillescene.com/site/forms/subscription_services
PRINT: nashvillesceneshop.com
CONTACT TO ADVERTISE: msmith@nashvillescene.com
EDITOR: prodgers@nashvillescene.com





























In my 35+ years living and working in Nashville, I’ve navigated the twists, turns and now expansive growth of this wonderful place. Let me help you make the best choices in your biggest investment — real estate. I’m so grateful for my clients’ great reviews, repeat business and continued referrals. I’d love the opportunity to help make your Real Estate Goals a reality! Buy • Sell • Invest
Proud to now be with Onward Real Estate, a locally owned and focused firm.



EDITOR-IN-CHIEF D. Patrick Rodgers
MANAGING EDITOR Alejandro Ramirez
SENIOR EDITOR Dana Kopp Franklin
ARTS EDITOR Laura Hutson Hunter
MUSIC AND LISTINGS EDITOR Stephen Trageser
ASSOCIATE EDITOR Logan Butts
AUDIENCE EDITOR Annie Parnell
CONTRIBUTING EDITOR Jack Silverman
STAFF WRITERS Julianne Akers, John Glennon, Hannah Herner, Hamilton Matthew Masters, Eli Motycka, Nicolle Praino, William Williams
SENIOR FILM CRITIC Jason Shawhan
EDITORIAL INTERN Noah McLane
CONTRIBUTING WRITERS Cat Acree, Sadaf Ahsan, Ken Arnold, Ben Arthur, Radley Balko, Bailey Brantingham, Ashley Brantley, Maria Browning, Steve Cavendish, Chris Chamberlain, Rachel Cholst, Lance Conzett, Hannah Cron, Connor Daryani, Tina Dominguez, Stephen Elliott, Steve Erickson, Jayme Foltz, Adam Gold, Kashif Andrew Graham, Seth Graves, Kim Green, Amanda Haggard, Steven Hale, Edd Hurt, Jennifer Justus, P.J. Kinzer, Janet Kurtz, J.R. Lind, Craig D. Lindsey, Margaret Littman, Sean L. Maloney, Brittney McKenna, Addie Moore, Marissa R. Moss, Noel Murray, Joe Nolan, Katherine Oung, Betsy Phillips, John Pitcher, Margaret Renkl, Daryl Sanders, Nadine Smith, Ashley Spurgeon Shamban, Amy Stumpfl, Cole Villena, Kay West, Nicole Williams, Ron Wynn, Kelsey Young, Charlie Zaillian
ART DIRECTOR Elizabeth Jones
PHOTOGRAPHERS Angelina Castillo, Eric England, Matt Masters
GRAPHIC DESIGNERS Sandi Harrison, Tracey Starck, Mary Louise Meadors
GRAPHIC DESIGN INTERN Taylor Stringer
PRODUCTION COORDINATOR Christie Passarello
MARKETING AND EVENTS DIRECTOR Robin Fomusa
EVENTS MANAGER Tristan Maryanski
BRAND PARTNERSHIPS AND EVENTS MANAGER Alissa Wetzel
MARKETING AND PROMOTIONS MANAGER Meredith Grantham
PUBLISHER Mike Smith
ASSOCIATE PUBLISHER Michael Jezewski
SENIOR ADVERTISING SOLUTIONS CONSULTANTS
Teresa Birdsong, Olivia Britton, Carla Mathis, Heather Cantrell Mullins, Niki Tyree
ADVERTISING SOLUTIONS CONSULTANTS
Kailey Idziak, Allie Robbins, Andrea Vasquez
SALES OPERATIONS MANAGER Chelon Hill Hasty
ADVERTISING SOLUTIONS ASSOCIATES Audry Houle, Jack Stejskal
SPECIAL PROJECTS COORDINATOR Susan Torregrossa
PRESIDENT Mike Smith
CHIEF FINANCIAL OFFICER Todd Patton
CORPORATE CREATIVE DIRECTOR Elizabeth Jones
IT DIRECTOR John Schaeffer
DIGITAL DIRECTOR Caroline Prater
CIRCULATION AND DISTRIBUTION DIRECTOR Gary Minnis FW PUBLISHING LLC
37206. Phone: 615-244-7989. The Nashville Scene is published weekly by FW Publishing LLC. The publication is free, one per reader. Removal of more than one paper from any distribution point constitutes theft, and violators are subject to prosecution. Back issues are available at our office. Email: All email addresses consist of the employee’s first initial and last name (no space between) followed by @nashvillescene.com; to reach contributing writers, email editor@nashvillescene.com. Editorial Policy: The Nashville Scene covers news, art and entertainment. In our pages appear divergent views from across the community. Those views do not necessarily represent those of the publishers. Subscriptions: Subscriptions are available at $150 per year for 52 issues. Subscriptions will be posted every Thursday and delivered by third-class mail in usually five to seven days. Please note: Due to the nature of third-class mail and postal regulations, any issue(s) could be delayed by as much as two or three weeks. There will be no refunds issued. Please allow four to six weeks for processing new subscriptions and address changes. Send your check or Visa/MC/AmEx number with expiration date to the above address.
In memory of Jim Ridley, editor 2009-2016







































































AJ Capital has turned the area into a construction site. Will a neighborhood emerge?
BY ELI MOTYCKA
INCONVENIENCE STARTED AS an asset for Wedgewood-Houston. It’s close to downtown and owes its warehouses to a central train yard, but it’s hostile to traffic — there are two inefficient ways in and one good way out, and no reason to cut through. A little corner of the city grew here at the foot of St. Cloud Hill between the highways and railroads, moving through a now-familiar gentrification rhythm: from last century’s pasture to single-family plots to industrial sites that became affordable and inhabited by Nashville’s creative class in the early 2000s. Around that time, when getting the copper stripped from an HVAC system was a regular nuisance for property owners, punk and hardcore bands played area hotspots like Little Hamilton and visual artists worked out of Fort Houston and The Packing Plant — the latter still an active community arts space on Hagan Street. Contemporary arts galleries from David Lusk (David Lusk Gallery) and Manuel Zeitlin (Zeitgeist) moved into the area, and the Nashville Sounds moved from Greer Stadium — once the area’s signature landmark — to First Horizon Park in Germantown. (Greer’s iconic guitar-shaped scoreboard now lives a few hundred yards down Chestnut Street as a lawn ornament outside Live Nation corporate offices.) At some point, people started calling the area “Wedgewood-Houston” for its north and south boundary roads, a brand popularized by the area’s art crawl.
Bigger money followed. The arts culture became a primary selling point for corporate developers — none with a grander vision, greater impact or bigger checkbook than AJ Capital Partners, which moved its headquarters from Chicago to the old May Hosiery building in 2020. With almost $6 billion in assets across the U.S. and Europe, the company specializes in rehabilitating old properties for a luxury market. Its master vision is Wedgewood Village, an 18-acre campus with more than 1.6 million square feet of mixed-use space that builds “upon the fabric of Wedgewood Houston as a crossroads for culture and commerce,” according to marketing materials.
To get there, AJ has turned the neighborhood into a building site. A small army of contractors and construction workers gets first dibs on the area’s free parking each morning, ushering in the day’s chorus of noise and debris. During business hours, cars crawl through Wedgewood-Houston like a labyrinth, avoiding bucket trucks and men in hard hats pointing at the sky. Foot traffic, the lifeblood of local retail, has not materialized despite hundreds of local apartment units, many of which struggle with double-digit vacancy rates.

Even if a new, shining neighborhood has been promised on the other side, some people in the area aren’t sure if they can make it there. The speed and scale with which AJ has pursued its singular vision have frustrated longtime residents who built the area’s cultural selling points. Many smaller independent businesses, specifically galleries and recording studios, are struggling to find a new equilibrium with the powerful corporation — akin to a Wedgewood-Houston “overlord,” one artist tells the Scene — working on its own timeline.
“It’s like we’re operating with an arm tied behind our back financially,” says Loney John Hutchins, a recording engineer who bought 444 Humphreys St. in 2011 to turn the duplex into a professional downstairs studio. Artist Julia Martin has a gallery upstairs. “I think AJ is a net positive when you consider alternative developers, but we’re on round three of ‘tear shit up,’ and we all thought things would be more settled by now. This last year in particular has been the hardest for me as the property owner.”
Jackhammers and blasting are prohibitive obstacles for Hutchins’ recording studio. Rapid high-dollar investment also jacked up his property taxes after this year’s reappraisal, an inadvertent city burden that threatens to drive out the “little guy,” Hutchins says.
Crowded parking, construction debris and piled-up street trash — left by city waste management, which irregularly services the area due to construction obstacles — further discourage an otherwise pleasant and walkable pocket of Nashville. Clothier Savas, new Italian deli Ingrassia & Sons, and Julia Martin Gallery all set up in the area betting on a healthy neighborhood with regular walk-in customers, not years of cranes and scaffolding. Many local favorites have left, like Earnest Bar & Hideaway and Claw-
Pub & Deli.
More than a decade ago, a raging party at Jon Sewell’s Chestnut Street house earned Sewell a visit from neighbor Roger Moutenot the next day. Moutenot, a legendary rock producer with a nearby studio, told him to keep things clean and pick up after his guests. In other words: Be a good neighbor. Over 15 years, Sewell — a former union carpenter — remodeled his 130-yearold house into a towering work of art full of tacked-on half-stories and nooks resembling a real-life version of The Burrow, home to the Weasley family in the Harry Potter series. Sewell turned another lot down Hagan Street into The Packing Plant, a home for arts efforts like WXNA-FM and Coop Gallery.
“It’s these small-time places whose social capital subsidizes the developers,” Sewell tells the Scene in his kitchen. “People want to be around things cooler than them, and artists are cooler than them. AJ seems to at least have an inkling of what they’re doing here. They pretend they’re adding to this arts ecosystem, but they want to create a new one — I mean, there are things with French names coming in. I think we can coexist because clearly there’s a mutually beneficial arrangement here, but is this even a neighborhood anymore? We have to figure it out together.”
Fifteen years ago, Sewell apologized to Moutenot for a few beer bottles left strewn around his house. Three years ago, Sewell spoke at a planning commission meeting encouraging AJ to do an archaeological survey across the street before starting excavation for a new project; Sewell quickly pulls up a picture of the AJ Capital rep staring at his phone during Sewell’s prepared remarks, seemingly ignoring him. The survey didn’t happen. While he can see them from his top-floor deck, Sewell hasn’t been
“
“I THINK AJ IS A NET POSITIVE WHEN YOU CONSIDER ALTERNATIVE DEVELOPERS, BUT WE’RE ON ROUND THREE OF ‘TEAR SHIT UP,’ AND WE ALL THOUGHT THINGS WOULD BE MORE SETTLED BY NOW.” —LONEY JOHN HUTCHINS
invited to AJ Capital parties either — a simple gesture regularly extended even to neighbors you don’t like, Sewell says.
These small incidents of neighborly grace, or lack thereof, seem to impact Hutchins, Sewell and other longtime area residents just like the concrete inconveniences of parking or blasting. They also threaten to make or break ongoing neighborhood diplomacy between newcomers and their predecessors, the people who refashioned the neighborhood with a little money and a lot of effort. Along with, or maybe in spite of, a new Hermès store and the members-only Soho House, AJ Capital may not even know how badly it needs independent creative culture to credibly claim Wedgewood-Houston as an arts district. The Scene spoke with a representative from AJ Capital in reporting this story, but AJ did not provide an on-the-record statement in time for publication.▼
As MNPS heightens safety measures, student concerns persist
BY JULIANNE AKERS
IN RECENT MONTHS, Metro Nashville Public Schools has made numerous changes to safety measures in an attempt to prevent violence in schools. But as these modifications are implemented, some students continue to have concerns about their safety.
It’s impossible to have a discussion around school safety in Nashville without acknowledging the area’s recent tragic history. In 2023, three students and three faculty members were killed in a shooting at the Covenant School, a private Christian school in Green Hills. On Jan. 22 of this year, 16-year-old Josselin Corea Escalante was killed in a shooting at Antioch High School. (MNPS approved a $300,000 settlement for Escalante’s family at a school board meeting earlier this month.)
Both incidents sparked major protests at the Tennessee State Capitol pushing for gun violence prevention, though few statewide provisions related to the matter have been passed since. And due to resistance from Tennessee’s Republican supermajority, it’s unlikely that any major gun reform legislation will be approved anytime soon.
Meanwhile, MNPS has taken steps to enhance safety and security in local schools. In February, MNPS approved a $1.25 million annual contract for Evolv, an AI-powered weapons detection system, to be implemented in all local high schools. This was followed by a $1.2 million pilot expansion to install Evolv in middle schools, which was approved in September. This comes despite the fact that Omnilert, the AI-operated weapons detection system used at Antioch High School on the day of the January shooting, failed to detect the gun used.
MNPS has maintained that protocols like weapons detection systems are a part of a “layered approach” to school safety, citing other security technology, staff training and community partnerships as a part of a larger methodology toward ensuring safety in schools. School resource officers, security vestibules and shatter-resistant film are among other steps being taken by MNPS, along with advocacy and peace centers that focus on de-escalation and restorative practices.
Another safety feature currently being installed in MNPS schools is the Audio Enhancement system, which is designed to project a teacher’s voice throughout the classroom but also allows the teacher to alert the school administration of any threats or danger. MNPS spokesperson Sean Braisted says all middle and high schools currently have this system, as well as many elementary schools. Braisted says MNPS’ goal is to implement the system in all schools by the end of this school year.
This technology is similar to that of silent panic alarms used by teachers during the 2024
Apalachee High School shooting in Georgia. The alarms were credited with helping first responders arrive at the scene quickly, and state lawmakers are currently pushing for the rollout of these alarms in all Tennessee schools.
But despite these measures and protocols being carried out, some MNPS students feel there’s a lack of student input on what is being done about school safety. One local nonprofit, the Southern Movement Committee, pushes for youth voices in community conversations and Metro government decisions — including their recent efforts to create Metro’s Office of Youth Safety.
Gabrielle Lucas, a senior at Hume-Fogg Academic High School, is involved with the Southern Movement Committee. She tells the Scene that while the recent implementation of Evolv does increase her sense of safety at school, she worries that MNPS’ response is sometimes “reactionary” rather than addressing the root issues that may cause students to turn toward violence.
“I think a big part of it is they’re not talking to the ones that they’re trying to protect,” Lucas says.
“
“I THINK A BIG PART OF IT IS THEY’RE NOT TALKING TO THE ONES THAT THEY’RE TRYING TO PROTECT.”





“It kind of sends the message to me as a student that they believe Evolv is kind of all that it takes, which I don’t think is true,” she adds. Lucas says she’d like to see Metro schools put more emphasis on mental health programming and other initiatives to address students’ situations outside of school that might lead them to turn to violence.
Kaitlyn Saffell, a sophomore at John Overton High School, is also involved with the Southern Movement Committee and echoes Lucas’ concerns. She says it takes larger discussions around community support to create safer schools.
“We haven’t fostered environments where communities can thrive and actually depend upon each other,” Saffell says. “It’s kind of an individualism situation. We’re all [every] man for himself.”
While both students want Nashville’s youth to have a voice when it comes to local policymaking, Saffell says the constant conversations can take a toll on students’ mental health.
“I’ve had teachers tell me they would lay down their life for us,” she says. “I know it’s a whirlwind of emotions, and it can be very startling. It’s reassuring, but it also holds guilt because I don’t think we should have to worry about safety when you’re in an environment to learn. We’re all either minors or young adults, and that’s not our purpose of coming to school. And it can be very jarring.” ▼



















THE DAYS ARE SHORT, but the Christmas shopping lists are long. The cost of just about everything is up, while the people at the top don’t seem to be doing much to protect those at the bottom. The world feels like it’s on fire, and sometimes it’s hard to find the joy. But if you look for it, it’s there. And that’s largely thanks to the people in our community who do everything they can to care for the marginalized, the foodinsecure and all the others who haven’t gotten a fair shake.
In our cover package this week, our annual “Hey, Thanks” issue, you’ll find notes of appreciation from Scene staff and freelancers to community advocates, health care workers, waste management employees, librarians, school counselors and many others who share their light with the city. Read along with us — between screenings of The Last Waltz and bites of leftover-turkey sandwiches, of course — as we at the Scene look at Nashville and say, “Hey, thanks.”
—D. PATRICK RODGERS, EDITOR-IN-CHIEF
The group advocates for restorative justice programs and community center programming
THANK YOU TO good folks like Erica Perry, Mike Floss, Aaron McGee and the many volunteers and youth at the Southern Movement Committee for their continued commitment to the SMC’s Varsity Spending Plan. The plan advocates for allocating public funds to an Office of Youth Safety, restorative justice programs and community center programming.
In 2024, the Metro Council approved $1 million to staff the Office of Youth Safety and to enhance programs offered at the Napier Community Center. In 2025, a substitute budget proposal included nearly $1.7 million for the Office of Youth Safety and additional community center programming.
I first interacted with Floss last year, when I was working on a magazine being released by my college newspaper. While we haven’t personally kept up since, I have been sure to follow the strides the SMC has made in creating safer communities. The SMC is training the next generation of leaders. Youth who participate in the programs build confidence, understand how the government operates, and learn how to implement real change in their communities.
If you ever feel unsure about the future of our town, just watch one of the many clips of SMC members speaking at Metro Council meetings and let the dread dissipate, allowing hope to shine.
—Noah McLane
Editorial
Intern,
Nashville Scene
ON-STREET PARKING and the massive influx of La La Land-seeking latte lovers have made it pretty much impossible to drive from Hillsboro Village, where I live, to the Melrose Publix, where I want to go five times a week. Unless 12South denizens agree to either convert the neighborhood to exclusively one-way streets or parking only on one side of the street, it’s impossible for two midsize cars to pass each other while traveling east/west in 12South without risking the loss of a side mirror.
So your choices are either jousting straight at each other until someone chickens out, or instead, doing what polite drivers have learned to do. These kind souls engage in a sort of friendly game of “Frogger,” politely ducking perpendicularly between parked cars for an instant to make room for an oncoming traveler, or stopping to wave someone else forward from 100 feet away.
I know the urban planners of the then-Waverly-Belmont neighborhood couldn’t have anticipated these difficulties when they ran the streetcar line down 12th. It was an eminently walkable neighborhood back then, and no one would have predicted that cross streets needed to be at least 35 feet wide to accommodate two Tesla Cybertruck phallic extensions parked on different sides of the street while two more attempt to travel in opposite directions down the same road. The sort of rigmarole required to travel the side streets would be unheard of in most neighborhoods. But in 12South, it’s the only way to pick up your damned Pub Sub before it gets cold!
—Chris Chamberlain Contributor, Nashville Scene
To the workers who help do the city’s dirty work with patience and expertise
NOTHING CAN THREATEN to destroy one’s entire day like the unknown time commitment of a disposal errand. The abrupt closure of Metro’s East Convenience Center for a decent stretch this fall turned routine trips to East Trinity Lane into battles across midday Nashville traffic to Omohundro or Ezell Pike.
Staff members at convenience centers seem to get it on a spiritual level, often taking extra care to pick up the overflow and sense, then defuse, building frustration among the day’s never-ending waves. The varied and dangerous items that come through also require a certain expertise — which workers at the now reopened East Convenience Center seem to have instinctively — meant to safeguard you, themselves and the unseen next link in the shared disposal chain.
Every day, Nashville’s recycling and waste center employees make mattresses, oil-based paint and lightbulbs full of mercury vapor disappear responsibly, simultaneously incinerating would-be bad days with an extra helping hand or pithy comment. Thanks for helping do the dirty work.
—Eli Motycka Reporter, Nashville Scene
To the people who shoulder the immense burden of keeping me safe in the sky
I’VE ALWAYS HATED heights, and I’ve spent most of my life so far boarding a plane only when it is absolutely necessary — and even then, I tend to stay in low-key terror. When I fell in love with my wife, who is passionate about traveling, I resolved to cope with my fear of flying so I could really engage in this part of our relationship and one day maybe actually enjoy it. Talking with my therapist, taking anti-anxiety medication and also just kinda flying more have all really helped. (Pro tip: Reading extensively about air disasters satisfied my curiosity but did not help here.) I’m proud to say that after seven years, I am finally looking forward to trips without having to tamp down existential dread when I see a flight on our shared calendar.
I have always taken solace in knowing that I’m more likely to have a serious accident on the way to the airport than I am to be involved in an air crash. This is a statistical fact because of a lot of people’s hard work, and air traffic controllers deserve a ton of the credit.
Ronald Reagan made hay and politicized the profession with the breaking of the 1981 PATCO strike. By the end of the most recent government shutdown, the air traffic controllers who could stay on the job were doing so with no pay, and the Federal Aviation Administration had to reduce the number of flights at many airports, including Nashville International. This brought into sharp relief the overall shortage of these vital workers whose training absolutely has to be extensive, in some cases taking years.
With effort to take care of myself and a little luck, I have half my life left to explore far-off places with my family thanks to the miracle of flight. I’m deeply grateful to the crews in the towers who make it so I can think about things like picking out toys that don’t make too much noise for my kid to play with and remembering sunscreen.
—Stephen Trageser
Music Editor, Nashville Scene


The grown-ups-only maker space lets you create like a kid
ONE OF THE THEMES of my year has been nurturing the parts of my brain that thrive in process, rather than product. I report and write every day on deadline, so I need ways to be creative and make stuff without feeling like I have to finish it. Plus, the more I make things with my hands, the less I doomscroll.
I should have known that poet, artist and “creativity whisperer” Stephanie Pruitt Gaines would have the answer. She opened The Creativity Bar in an unassuming strip mall in Donelson, at an intersection I drive through every time I head to Percy Priest Lake to paddleboard. Instead of driving by, I parked and headed to an awkward doorway under a big clock. Then I walked through the bright rainbow hallway into a large black-and-white room that was painted to look and feel like a giant coloring book … and I was the crayon. Immediately, I felt simultaneously energized and soothed. On Mondays through Thursdays from 4 to 8 p.m., Gaines holds a $10 Creative Happy Hour. Show up, grab a seat and talk to strangers while you draw, color, solve puzzles, make jewelry or do any manner of other creative pursuit with goodies from The Creativity Bar’s many bins and shelves of supplies. If you don’t want to talk to anyone else, you can flip a sign over on the table in front of you to request some solo focus time.
(Imagine if cocktail bars had this!)
When Creative Happy Hour isn’t taking place, The Creativity Bar is open for semi-private parties, team-building and workshops (which Gaines calls “playshops”). Some are focused on making something such as earrings, while others, like R&B coloring night, are just about the creative vibes. Everything at The Creativity Bar is for adults — not because the activities are inappropriate for those under 21, but because kids get myriad opportunities to play and create and color with low or no stakes. Gaines wants adults to have that same experience. I can’t tell you one single thing I made at Creative Happy Hour (one of them involved a pipe cleaner, I think). But it doesn’t feel like time wasted, and for that I am grateful.
—Margaret Littman Contributor, Nashville Scene

The Nashville Public Library’s Edmondson Pike branch is always teeming with neighbors and kids from area schools
THERE’S SOMETHING ABOUT a neighborhood library that makes you feel rooted in a place. Maybe it’s the friendly faces behind the front desk, or the enthusiastic response you receive when you show up at a library event. Maybe it’s just the comforting and familiar smell of all those books.
Celebrating 25 years this December, the Nashville Public Library’s Edmondson Pike branch is always teeming with neighbors and kids from area schools. And the programming is so above and beyond what you might expect — crafting sessions for tweens, Dungeons and Dragons sessions for teens and adults, a zine club, story time, yoga, crochet, reading-withdogs events … the list of activities is kind of unreal. The library staff updates the branch’s website and Instagram profile with event details and more. The library is an amazing resource for neighborhood-building and access to whole new worlds — via both books and activities — right in our South Nashville community. Don’t ever change, Edmondson Pike branch!
—Elizabeth Jones
Art
Director,
Nashville Scene



Your first-time homebuyer course helped me and my wife navigate the daunting prospect of purchasing a house
I NEVER REALLY envisioned myself as a homeowner, and feel a little bit like a sellout. The housing system in this country feels so broken: The people who need the stability of ownership are rarely in a situation to attain it, and infuriating reports about corporations competing with normal families on the increasingly expensive market makes me want to scream! But I was also getting tired of renting, and my wife and I needed more room for our high-energy puppy. For all the half-baked anticapitalist rants I am prepared to unleash, I must admit: The process also intimidated me. I had no clue where to start, who to contact or whether I should even bother trying. But thankfully New Level CDC had a class for newbies.
The first-time homebuyer course is a oneday mega-lecture that walks you through the steps of how to buy a house, from getting your savings in order to finding a real estate agent to getting insurance. The step-by-step instruction is easy to follow, and each section of the course is taught by someone you can actually work with — it feels less intimidating walking into a bank when you’ve already met the loan officer. The class is taught in the basement of Mt. Zion in North Nashville, and also caters to folks who might be the first homeowners in their families. We took the class in April and closed in November, and we love our new home. So here’s a big thanks to instructor Antoinette Jenkins and her dream team: financial coach Tonesha Talley, loan officer Marie Holmes, real estate agent Denise Moore, home inspector Julian Lindsey and insurance agent Celestia Ware.
—Alejandro Ramirez Managing Editor, Nashville Scene
Their work can save our lives as individuals — and might even save our species
YOU MAY Be alive thanks to basic research. The entire scientific community came together in 2020 to tackle a new virus known as COVID-19. The scientists developed new therapies and vaccines in an almost impossibly short time, saving the lives of millions around the world. (Nashville generated two high-profile faces of the fight: virologist Dr. James Hildreth of Meharry Medical College — named Nashvillian of the Year by the Scene in 2021 — and infectious disease specialist Dr. William Schaffner of Vanderbilt University Medical Center.)

The COVID vaccine was born from initial research that occurred in the global scientific community in 2005, work that ultimately earned a Nobel Prize in 2023. That effort was successful due to the persistence of scientists who had to fight to continue their work. And speaking of Nobel Prizes, this year’s prize in economics went to researchers who showed the critical role that science and technology play in the economic growth and prosperity of societies. That benefit goes far beyond medicine: America’s research institutions study multifarious topics, ranging from astronomy and chemistry to mathematics and, crucially, climate science — the last of which has the potential to save civilization from itself.
It seems self-evident that scientific research is vital to humanity’s survival, but there are forces that can’t handle the truth, forces that undercut research with draconian budget cuts. We give thanks to the scientists who continue to work undaunted through difficult times — their perseverance gives us hope for the future.
—Dana Kopp Franklin Senior Editor, Nashville Scene
These MNPS employees are on the front lines, supporting tens of thousands of students in Nashville
WHETHER IT’S HELPING students navigate issues in their personal and family lives or guiding them through college applications, public school counselors work tirelessly everyday to ensure every student has a support system.
This year hasn’t been easy for students in Nashville: 2025 began with a fatal shooting at Antioch High School, heightening anxieties around school safety for students and their families. Meanwhile, the mental health of children across the state is worsening. According to the 2024 “State of the Child in Tennessee” report, more than 1 in 4 high school students say their mental health is mostly or always not good. Nearly the same amount reported seriously considering taking their own lives.
Throughout all of this, school counselors have been on the front lines supporting tens of thousands of students in Nashville, some of whom would not otherwise have ready access to mental health services.
The 200-plus counselors in Metro Nashville Public Schools are able to provide short-term counseling to students, and can refer them to long-term support providers. Their efforts help minimize some of the stressors faced by local students, all so they can remain focused on their education. Thanks to our area’s school counselors for helping create a healthier and more equitable community for everyone.
—Julianne Akers
Reporter, Nashville Scene and Nashville Post





Finding community through cult classics at the beloved theater’s late-night screening series
WHEN I MOVED To Nashville from Richmond, Va., this year, I mourned the loss of the Byrd Theatre, my neighborhood’s historic movie palace. Since then, I’ve been happy to find a home at the Belcourt — and as someone raised on late-night public access TV and so-bad-it’s-good hate watches, I was particularly thrilled to discover their midnight screening series of cult classics, Belcourt Midnights.
We’re big fans of the Belcourt’s Halloweentide marathon 12 Hours of Terror here at the Scene, but through Belcourt Midnights, the theater showcases thoughtfully paired screenings of the finest in oddball cinema year-round. With a focus on nostalgic and out-there releases, there’s a heavy horror presence, but also plenty of films for the faint of heart. Earlier this year the Belcourt screened The Brady Bunch Movie in conjunction with Scooby Doo, and the Thanksgiving weekend series pairs the goofy action-comedies The Big Lebowski and Big Trouble in Little China
Alongside the series’ expert curation, Belcourt Midnights excels at bringing these films’ passionate fandoms to life through preshow programming. This year, their annual screening of The Room in 35 mm featured a Q&A with co-producer and actor Greg Sestero (oh hi, Mark!), live line readings from the original script and special previews of forthcoming The Room content. They’ve hosted VHS exchanges, concocted themed drinks, run costume contests — all with the mission of bringing people together, and hyping them up to share an experience of good (or bad!) cinema.
I’m proud to count myself among those who have made friends with fellow aficionados in the Belcourt Midnights popcorn line, and I’m looking forward to seeing what they have in store for the new year. Maybe they’ll let me pitch my personal dream combo: Tremors and David Lynch’s Dune
—Annie Parnell
Audience Editor, Nashville Scene
MARGINALIZED COMMUNITIES’ FIGHT for equality isn’t a one-time battle. It’s an ongoing struggle that slowly but surely helps move the needle toward justice. That struggle can be particularly difficult for LGBTQ folks amid a political climate that at best often refuses to acknowledge queer people’s existence — and at worst foments violence.
For more than two decades, Nashville-based nonprofit the Tennessee Equality Project has been advocating for the rights of LGBTQ Tennesseans. Sometimes that means responding to Republican-backed legislation often referred to as the annual “Slate of Hate” — bills that aim to do things like limiting gender-affirming care for young trans people or even banning Pride flags in public schools. Sometimes it means compiling research and plans for action, or organizing town hall events. And sometimes it means hosting and funding joyful community-building events like this year’s BoroPride in Murfreesboro when corporate sponsorship dried up.
So thank you to the folks at the Tennessee Equality Project for sticking their necks out when it matters. And thank you, importantly, for helping provide sources of joy with your Pride celebration efforts, especially in parts of the state where being out and proud isn’t always celebrated.
—D. Patrick Rodgers Editor-in-Chief, Nashville Scene


The 50-year-old organization sees immense change, and continues to produce success stories
THE TENNESSEE COUNCIL on Developmental Disabilities celebrated its 50th anniversary this year — in that time span, the agency saw lots of changes for the community it serves. In 1975, many people with disabilities lived in institutions away from their families; children with disabilities often couldn’t attend their neighborhood school; finding a job or living independently was often not within reach for disabled people.
One way the independent state entity makes change is through its Partners in Policymaking program, a free program that trains people with disabilities and their families to be advocates. Chrissy Hood, a graduate of the program, spent years advocating for access to adult-size changing tables. After several years of diligent work, Tennessee became the first state to offer adult changing tables in all of its state parks. It’s Hood’s lived experience, plus the confidence and training infused by the council, that enabled this change and others like it.
While Tennessee is often behind compared to other states on matters of health care, the council’s work allows the state to be ahead in some disability matters. Tennessee was ahead of the curve in closing outdated residential institutions for people with disabilities and later, offering tech-centric programming. And when the state is behind, members of the council get involved: In the passage of the Katie Beckett Program, which helps pay for care for children with disabilities regardless of income, council members participated in a 72-day sit-in to get it passed.
The Coalition on Developmental Disabilities is the place to go for information, like the Disability Pathfinder directory (in partnership with the Vanderbilt Kennedy Center). I even subscribe to their free print product, Breaking Ground magazine. The work all falls under a simple guiding principle: self-determination, the ability to make your own choices about your future.
The council’s work also serves to remind me that advancements like the 1990 Americans with Disabilities Act were painfully recent, and we have a long way to go to make sure people with disabilities are thoroughly included in the community. I keep going back to the Council on Developmental Disabilities in my work as a reporter, because the group teaches me about the difficulties people with disabilities face, while also offering lots of examples of how they thrive.
—Hannah Herner Reporter, Nashville Scene


















NOVEMBER 28, 29 & 30
BRETT ELDREDGE GLOW LIVE
DECEMBER 1, 2, 3 & 4
LITTLE BIG TOWN THE CHRISTMAS SHOWS
DECEMBER 6
SANTA AT THE RYMAN PHOTOS WITH SANTA ON THE RYMAN STAGE
DECEMBER 9
SARAH BRIGHTMAN A WINTER SYMPHONY
DECEMBER 10, 11, 13, 14, 17, 19 & 20
AMY GRANT & VINCE GILL CHRISTMAS AT THE RYMAN
DECEMBER 12
LEANN RIMES GREATEST HITS CHRISTMAS
DECEMBER 15 A PRAIRIE HOME COMPANION CHRISTMAS
DECEMBER 21, 22 & 23
LADY A THIS WINTER’S NIGHT
DECEMBER 28 A DRAG QUEEN CHRISTMAS

The Nashville food bank’s grocery-style experience offers aid — and agency
WHEN MY PARTNER and I lost our apartment in a devastating fire this year, we had to throw away all the food we had in the house. I’m talking pantry goods, things in the fridge and freezer, the bottle of wine I was saving for a special occasion — everything edible was exposed to dangerous smoke and fumes, so everything had to go.
Expenses pile up when you have to toss or deep-clean everything you own, and restocking an entire kitchen is no easy task. That’s why it was a godsend when the Red Cross packed our pantry with a one-time trip to The Store, a Nashville nonprofit that offers food aid with a dignified, grocery-store-style “shopping” experience. Founded by Brad Paisley and Kimberly Williams-Paisley, The Store goes beyond the traditional food bank model, focusing on fresh foods, choice and healthy options.
As a shopper at The Store, you’re given a budget of shelf-stable goods, proteins and fresh produce — and the agency to customize your list to your family’s tastes and needs. Beyond food, they also offer toiletries, household necessities and seasonal items. When we went in September, they had back-to-school supplies available, and this holiday season they’re hosting The Toy Store on Dec. 5 and 6. Plus, their wraparound services like counseling and financial planning help set up their clients for long-term stability and success.
Food insecurity can look a lot of different ways, and with the ongoing uncertainty about SNAP benefits, The Store’s work is more important than ever. So thank you, The Store, for turning a disheartening experience into an affirming one, and for the support you offer Nashville families every day.
—Annie Parnell
Audience Editor,
Nashville Scene
To the team who guided my newly expanded family through critical early days
EVERY BIRTH IS different, but people seem to agree the experience is typically an overwhelming rush. That was certainly the case for my wife and me when we welcomed our son to the world in February, and we had fantastic support from Vanderbilt University Medical Center’s birth center staff and our doula to help us navigate it. But you don’t hear quite as much about the people who help new parents cope with the next phase: the postpartum hospital stay. They also are absolutely crucial to leaving the facility with a healthy baby and some semblance of confidence that you will be able to care for them.
When our boy made his grand entrance, we’d already been at the hospital for about 18 hours. Emmett needed a relatively short stay in the NICU, so it took another four or five anxious hours for us to get bonding time with him. Then there were still more than two days of recovery and observation, with tests and checks and official documents to sign at various intervals around the clock. All of this was overseen by kind, calm, patient nurses and other support staff — folks who eased into stressful situations with sentiments like, “Oh, you have the baby with the hair,” referring to our kid’s shockingly blond mane — in whose debt I’ll always be. Every step of the way, they were fully prepared to work with Mom, who’s given birth and also hasn’t slept in days, and Dad, who hasn’t slept either and is coping with his first simultaneous projectile vomit/blowout diaper/ pee fountain situation while just getting used to holding a tiny but miraculously fully functional human. And at the end of it, they checked over the car seat, made sure we were stocked up with supplies and rolled us — wide-eyed with wonder — to the door.
We are incredibly lucky and have lots of people to thank for bringing our son into this heartbreaking world surrounded by love. These are some of the first.

—Stephen Trageser Music Editor, Nashville Scene

The city’s long-running art gallery is closing, and we’re already feeling its loss
IF ZEITGEIST HAD done nothing more for Nashville’s art scene than provide representation for Alicia Henry — the best artist to ever call the city home, in my opinion — from 2001 until her death in 2024, it still would have been an indispensable institution. But Zeitgeist has provided generations of Nashvillians with great art for free, first at its original location in Cummins Station, then in Hillsboro Village, and finally in its Wedgewood-Houston location on Hagan Street, where it anchors a small but mighty art hub. When news broke in July that Zeitgeist would be shuttering at the end of the year, the community outcry had the same tenor — the same the-glory-days-are-over anguish — as during the closures of other formative Nashville spots like Lucy’s Record Shop and The Muse. So thanks, Zeitgeist, for the many years of remarkable exhibitions. Thanks for that wild Brent Stewart and Willie Stewart collaboration, where they parked a muscle car inside the gallery and played Neil Young’s Zuma straight through on the car’s stereo. Thanks for the retrospective of artists from North Nashville’s In the Gallery — guest curated by the great Carlton Wilkinson — which brought stalwarts Samuel Dunson, Barbara Bullock and Myles Maillie together one last time. Thanks for giving space to hometown-boys-made-good Wayne White and Kurt Wagner. Thanks for Vesna Pavlović’s first big solo photography installation, fresh from the Istanbul Biennial, which proved that slide projectors could still powerfully serve contemporary art. Thanks for introducing Alex Lockwood’s tortured plastic bodies, which had me writing about grief and pareidolia in an art review. And of course, thanks for making space for Alicia Henry’s bold, uncomfortable, intimate and otherworldly art works. We’re all better because they were here.
—Laura Hutson Hunter Arts Editor, Nashville Scene










EFFIN FRI, 11/28
NOAH GUNDERSEN SAT, 11/29
ARIEL POSEN THU, 12/4
MINI TREES FRI, 12/5
CHOKECHERRY SAT, 12/6
SAM GREENFIELD MON, 12/8
CONNOR KELLY & THE TIME WARP FRI, 12/12
GOTTMIK + VIOLET CHACKI FRI, 12/12
EMO NIGHT BROOKLYN SAT, 12/13
GLYDERS SUN, 12/14
HOUSE RAVE PARTY TUE, 12/16 A FOREIGNER’S JOURNEY TO BOSTON FRI, 12/19
BEAR GRILLZ FRI, 12/19
NOBIGDYL. FRI, 1/23
OLIVIA BARTON THU, 1/29










for more event listings

SATURDAY, NOV. 29
MUSIC
[YOUTH IN REVOLT] MAISY OWEN SINGLE RELEASE
First off, we at the Scene want to express our thanks and gratitude to all the folks out there sending us new music all year round. Did we listen to it all? There aren’t enough hours in the day. But 2025 was a wonderful year to be a listener, and we really appreciate y’all hipping us to cool stuff. Y’all are the best. That said, this new Maisy Owen single is a portent of great listening in the year to come. Her album comes out in May on the great guitar-focused Tompkins Square, a label that has worked with local pickers William Tyler and Luke Schneider. “My Youth Is All for You” has a finger style that is beautiful, sparse and dark around the edges; the lyrics have a bit of David Berman’s attention to detail, and the vocals remind me of early Sharon Van Etten and classic Tristen. It’s vibe that fits holiday-weekend Springwater like fingerless gloves on a frost-covered busker. SEAN L. MALONEY
9 P.M. AT SPRINGWATER SUPPER CLUB & LOUNGE
115 27TH AVE. N.
ART
[BIG FIGURES] MONUMENTAL HOLIDAY
In case you missed Monumental Figures at the Parthenon this summer — a larger-than-life installation from local sculptor Alan LeQuire and his capable band of assistant artists — the collection so kindly gives you another chance this holiday season. The project sprang from LeQuire’s desire to elevate people who have inspired him to the grand scale of sculpture, with a heavy emphasis on local figures like Wilma Rudolph, Diane Nash and young Olympians Alex and Gretchen Walsh. Circle Dec. 6, when LeQuire opens his Charlotte Avenue gallery for the West Nashville Art Crawl to show off select work from the titular exhibition. That day, the LeQuire Gallery will also feature work from artists Joan Curry, Bryan Rumfola, Twyla Lambert Clark, Daniel Leavitt, Martica Griffin and Juliette Aristides. ELI MOTYCKA THROUGH DEC. 31 AT LEQUIRE GALLERY 4304 CHARLOTTE AVE.
FILM
[I HATE THE EAGLES, MAN] MIDNIGHT MOVIES: THE BIG LEBOWSKI
Put on your robe, polish your bowling balls and sit down with a delicious white Russian for the Belcourt’s Midnight Movies showing of The Big Lebowski. The ’90s classic from the Coen brothers features Jeff Bridges in arguably his most iconic role — the Dude. In this love letter to vintage noir films, the Dude gets mixed up in a tale of conspiracy when he’s mistaken for a millionaire who happens to share his name. The Coens then dare to ask the question: What if the investigator at the center of the mystery was an idiot? Expect the unexpected with this treasure trove of characters played by legendary actors John Goodman, Julianne Moore and John Turturro, to name a few. Who knows — maybe some followers of Dudeism will show up to spread their wisdom, too. IAN MATTHEWS MIDNIGHT AT THE BELCOURT 2102 BELCOURT AVE.

[JUST CALL ME MR. BUTTERFINGERS]
EMO PHILIPS & TIM CAVANAGH
“A computer once beat me at chess,” begins one of Emo Philips’ best-loved one-liners. “But it was no match for me at kickboxing.” There’s a special kind of absurdity that connects Philips’ fans. With his pageboy haircut, turtleneck sweaters and flared trousers, he looks more like a musician from the psychedelic pop era than a stand-up comic. But Philips has been working on the periphery of comedy for nearly 50 years, crafting hilarious anecdotes told through his creaky voice. His style alternates between kindhearted innocence and a noir awareness that our human existence is inherently strange. But his hard work and his unique way of making people laugh have captured new fans over and over, through his frequent Letterman appearances, as a woodshop teacher who slices off his thumb in UHF, or his animated therapy sessions on Dr. Katz, Professional Therapist Given Philips’ long history of collaborations with Weird Al Yankovic, his current tourmate Tim Cavanagh seems like a logical partner. Cavanagh’s work got an early push from Dr. Demento for his satirical songs. And he was a longtime favorite on The Bob & Tom Show for his celebrity birthday segments. P.J. KINZER
8 P.M. AT THE LAB AT ZANIES
2019 EIGHTH AVE. S.
MUSIC
It’s hard to overstate the significance of the Grand Ole Opry’s role — for both better and worse — in defining the public identity of Nashville and capital-C Country Music, our city’s biggest cultural export. The show’s Opry 100 series has been celebrating the program’s centennial since late 2024 and will continue into 2026, but Friday’s pair of broadcasts are extra special: They mark 100 years to the day since radio station WSM premiered the WSM Barn Dance with fiddler Uncle Jimmy Thompson, which became the Grand Ole Opry a few years later. As contributor Margaret Littman wrote in her recent Scene cover story, the show’s trajectory hasn’t been a straight line, but it has maintained its status as a major cultural landmark. The lineup is the same for both early
and late shows, and as you might expect, they are packed to the brim with top talent. All the guests are Opry members and most have been well-known for many years, like Connie Smith, Marty Stuart, Suzy Bogguss, Charlie McCoy, Gary Mule Deer, Mandy Barnett, Vince Gill and Lorrie Morgan. Dustin Lynch and Scotty McCreery are well-established artists who are nonetheless a little newer to the scene, and they’re also slated to perform. STEPHEN TRAGESER
7 & 10 P.M. AT THE GRAND OLE OPRY HOUSE
600 OPRY MILLS DRIVE
FILM
[I WILL PAY YOU TODAY, SIR] RESTORATION ROUNDUP: BARRY LYNDON
For a long time, this was the only Stanley Kubrick movie I hadn’t seen. Barry Lyndon looked, on its surface, stuffier and less exciting than the legendary director’s edgy, countercultural lightning rods like A Clockwork Orange or genre explorations like The Shining Like many a young, male, burgeoning cinephile, I saw costumes and period trappings and a three-plus-hour runtime and ran in the opposite direction. What an embarrassing mistake. Like its buffoon of a titular character, Barry Lyndon is beautiful, hilarious and maddening

in equal measure. The innovative, sumptuous cinematography is the true star of the picture — every frame is indeed a painting. If, like the younger version of me, you’ve put this film off for too long, go see it rendered in a brand-new 4K restoration at the Belcourt like I did. You won’t be disappointed. See belcourt.org for showtimes. LOGAN BUTTS
NOV. 29 & DEC. 2 AT THE BELCOURT 2102 BELCOURT AVE.
I caught Nashville guitarist and composer William Tyler sitting in this summer with fellow guitarist (and Scene contributing editor) Jack Silverman and his band at Dee’s Country Cocktail Lounge in Madison. Tyler showed off his rock side amid Silverman and company’s jazz-meets-Jerry Garcia improvisations. After moving back to town during the COVID-19

pandemic following a stint in Los Angeles, the former Lambchop and David Berman collaborator has been busy, releasing two fulllengths in 2025 alone. Tyler worked with Four Tet auteur Kieran Hebden on 41 Longfield Street Late ’80s, which features Tyler’s post-New Age guitar on “When It Rains,” a track that moves from contemplative acoustic to scarifying electric guitar in five minutes. 41 Longfield Street and Tyler’s other 2025 album, Time Indefinite, are perfect records to listen to in the late fall, since they’re overtly nostalgic and a bit dark — high-level soundtrack music that only mimics what you might call easy listening. As well, Tyler has always paid tribute to the many tributaries of Nashville music, and I like his ability to, say, reference the 1970s instrumental band Area Code 615 on his krautrock-inspired tune “Area Code 601,” or recontextualize Bobby Charles’ “Tennessee Blues.” Saturday at The Blue Room, he’ll play in full-band mode, with plenty of electric guitar.
EDD HURT
8 P.M. AT THE BLUE ROOM AT THIRD MAN RECORDS 623 623 SEVENTH AVE. S.
ART [CRAFTY BASTARDS] THREADBARE: A GROUP EXHIBITION OF NASHVILLE
All art exists on some kind of a spectrum, but the widest range might be in the fiber arts. Everything from fashion design to craftmaking to conceptual art can exist under the umbrella of fiber art, and there are scores of extraordinary Nashville artists who work within the medium. The collaborative team at Coop has organized an exhibition of intergenerational artists called Threadbare that will celebrate a specific community of Nashville’s fiber artists. The crew is called Slostitch, and it began as an informal monthly gathering, but has evolved






















justin & the cosmics, jasmin kaset band, & the good country dark (9pm) hunter root (7pm)

Däs Grizzlies (7pm)
ascap gps showcase
zach meadows w/ zachary scott kline (7pm)

































































































9

6










into something the artists have called a dynamic exchange of techniques, stories and inspirations. Artists Melissa Beall, Caitlin Blomstrom, Theresa Buffo, Dorothy Dark, Jessica Eichman, Cary Gibson, Anna Saterstrom and Natalie Thedford will be showing work that explores the question: How do fabrics and textiles define us? The exhibition, which will be on view through Dec. 2, coincides with the Makers Bazaar — a community event held this weekend for Small Business Saturday.
LAURA HUTSON HUNTER
THROUGH DEC. 2 AT THE PACKING PLANT
507 HAGAN ST.
THEATER
[I WILL HONOUR CHRISTMAS IN MY HEART] MARK CABUS PRESENTS CHARLES DICKENS’ A CHRISTMAS CAROL
As much as I love a big glitzy holiday show, there’s something quite magical about a lone actor taking the stage for an intimate evening of storytelling. That’s just what Mark Cabus delivers with his acclaimed solo performance of Charles Dickens’ A Christmas Carol. Leaning into Dickens’ rich prose, Cabus portrays 18 different characters — from Ebenezer Scrooge to Tiny Tim — in a vibrant 75-minute adaptation that is sure to warm your heart. A veteran actor, director, writer and producer for stage and screen, Cabus has been a fixture in Nashville’s theater community for many years, performing with Nashville Rep, Nashville Shakespeare Festival and more. These days, this versatile artist is based in Indiana, serving as an assistant teaching professor of acting at Ball State University. But audiences can look for Cabus this weekend at the Darkhorse Theater, as he revives his delightful take on A Christmas Carol for one night only. It’s a master class in storytelling, and a marvelous way to kick off the holiday season. The performance is free, although donations will be accepted at the end of the evening to help cover expenses. AMY STUMPFL
7:30 P.M. AT THE DARKHORSE THEATER 4610 CHARLOTTE AVE.
SUNDAY / 11.30
FILM
[YOU’RE USIN’ MY OXYGEN] RESTORATION ROUNDUP: ONE FLEW OVER THE CUCKOO’S NEST
For the 50th anniversary of One Flew Over the Cuckoo’s Nest, the Academy Film Archive funded a 4K restoration of the Miloš Forman-directed, Michael Douglas-produced, multiple-Oscarwinning 1975 adaptation of Ken Kesey’s 1962 novel. Jack Nicholson won his first Oscar for his portrayal of a mental patient raising all sorts of liberating hell in an Oregon mental hospital. But I can’t help but think somebody at the Archive thought it would be a good idea to have this story of a rulebreaker encouraging a bunch of scared, traumatized folk (which includes future Taxi castmates Danny DeVito and Christopher Lloyd) to stand up to their soulless oppressors (led by Louise Fletcher’s memorably sinister ice queen Nurse Ratched) available for theaters to play during these dark, depressing, Donald-

filled times. Don’t be surprised if you end up sympathizing with these so-called crazy people, all of whom are craving some peace of mind in an environment controlled by bullies and tyrants (aka the real lunatics). Musician and Belcourt staff member Jessica Breanne will introduce the Sunday-morning screening. Visit belcourt.org for showtimes. CRAIG D. LINDSEY
NOV. 30 & DEC. 3 AT THE BELCOURT 2102 BELCOURT AVE.
MONDAY / 12.1 MUSIC
[DEEP POOL] LITTLE BIG TOWN: THE CHRISTMAS SHOWS
Nashville pop-country band Little Big Town marked 25 years as a group in 2024, and good for them. Pop country doesn’t come much lighter on its feet than Little Big Town’s music, and if you’re not a fan I couldn’t tell you where

















MONDAY,
Join

to start. I’d suggest “Pontoon,” from their 2012 album Tornado, or you might go back further to “Evangeline,” a song from 2007’s A Place to Land Like a lot of mainstream country artists, Little Big Town makes records that use the deep pool of pop-savvy songwriting and production talent Nashville is known for. This means you can scan the credits of their albums and see names like Lori McKenna, Natalie Hemby and Daniel Tashian, all of whom have written for Little Big Town. In fact, Tashian helps turn the title track of 2022’s Mr. Sun into a piece of unclassifiable pop, and there’s a similar vibe to the tracks Tashian worked on for 2020’s Nightfall, including the gorgeous “Bluebird.” The group’s vocalists — Karen Fairchild, Kimberly Schlapman, Phillip Sweet and Jimi Westbrook — achieve their own unique blend, and they also know how to write and pick good songs. Monday, they settle in for a four-night stand at the Ryman, and expect the shows to be a comprehensive tour of pop country.
EDD HURT
DEC. 1-4 AT THE RYMAN
116 REP. JOHN LEWIS WAY N.
If you’re a fellow card-carrying member of the Michael Mann-dom, then make your way over to the Belcourt for Thief. Showing as part of both Music City Mondays and the latest Restoration Roundup — and with a new 4K digital restoration approved by the maestro himself — Thief is the Mann ur-text, full of rain-slicked streets, neon nightscapes and competent but socially inept criminals. Thief stars a cool-as-hell James Caan as a professional safecracker named Frank who takes a high-stakes, high-paying gig for the Chicago mob … but the mafia, of course, has more plans for Frank than he realizes. Caan is joined by an inspired collection of grizzled supporting players, including local favorite Willie Nelson in one of his most notable film roles. See belcourt.org for specific showtimes.
LOGAN BUTTS

































Patrick Dailey, Mike “Grimey” Grimes (of Grimey’s New & Preloved Music), Katie Pruitt and Devon Gilfillian. As always, Portara has committed to giving 100 percent of its concert proceeds directly to its community partners. And this concert benefits MashUp! — a terrific organization dedicated to “improving the lives and wellbeing of Black LGBTQ+ people through education, advocacy and community-driven solutions.” AMY STUMPFL
DEC. 1 AT EASTSIDE BOWL
1508A GALLATIN PIKE S., MADISON

[HOWLIN’ FOR YOU] THE MATING GAME RELEASE PARTY
DEC. 1 & 6 AT THE BELCOURT 2102 BELCOURT AVE.



Freddie Mercury’s death from AIDS-related complications in 1991 brought global attention to the fight against HIV and AIDS, helping raise awareness and promote understanding. Just months after Mercury’s passing, the remaining members of Queen founded the Mercury Phoenix Trust and organized the Freddie Mercury Tribute Concert for AIDS Awareness at Wembley Stadium, raising millions for AIDS research and other charitable projects. So it seems particularly fitting that Portara Ensemble is marking World AIDS Day 2025 with One Vision: A World AIDS Day Tribute to Queen. Presented at Eastside Bowl on Dec. 1, the show will feature The Getdown Band (led by the fabulous Viktor Krauss) with a full choir. Audiences can also look forward to some big guest performances, including Sam Gyllenhaal,
If a love story about two wolf-shifters with a grumpy/sunshine dynamic sounds intriguing (and why wouldn’t it?), The Mating Game by Lana Ferguson should definitely be your next read. Ferguson, author of The Nanny and The Fake Mate, is known for writing paranormal and contemporary romance stories, and returns with her latest release on Dec. 2. To celebrate, The Coastal Cowboy Romance Bookstore is hosting a launch party at its new residency location. Located upstairs at Forevermore Coffee in East Nashville, the bookstore is dedicated to carrying a wide variety of romance titles. Be sure to grab a ticket to the event, which can include a copy of the book, plus a few other event goodies. The dress code is “inner creature of the night,” to keep the fantasy vibes going. Follow the store on Instagram (@coastalcowboybooks) for more news on other release parties and community events. TINA DOMINGUEZ
6 P.M. AT
400









11.1







From platinum-selling chart-toppers to underground icons, household names to undiscovered gems, Chief’s Neon Steeple is committed to bringing the very best national and regional talent back to Broadway.
From pla hif’N h t





Take Me To ChurchCelebrates the 10th Anniversary of “Mr. Misunderstood”
11.5 Eric Paslay’s Song in a Hat w/ Charles Kelley
11.6 Jamie O’Neal, Emily West, Sarah Buxton
11.12 The Kentucky Gentlemen –Rhinestone Revolution Tour
11.13 Anthony Gomes
11.17 Quartz Hill Records / Stone Country Records Take Over - 2 Lane Summer, Annie Bosko, Dusty Black, Matt Cooper, Ben Gallaher, Spencer Hatcher, Lakelin Lemmings
11.18
Chief’s Outsiders Round w/ Skyelor Anderson & Ben Kadlecek with Guests Chris Andreucci, Cody Atkins, Chris Hatfield, Jeff Holbrook
11.20 Uncle B’s Damned Ole Opry Presents: A Tribute to the Eagles w/ Dan Tyminski, Sierra Hull, Trey Hensley, Shaun Richardson, Thad Cockrell, Bryan Simpson
11.24 Buddy’s Place w/ The Heels, Preston James, Jack McKeon
11.29 Casey Chesnutt
1.21 Jamie O’Neal Gypsum Album Release Show





Gay, Do Crime is a daily history of queer resistance and resilience
BY MARIA BROWNING

THE LGBTQ COMMUNITY has long struggled for respect, acceptance and safety in the face of a hostile society, but the struggle has been marked by courageous — even joyful — resistance and resilience. Be Gay, Do Crime surveys the history of that resistance through a daily catalog of notable events.
In this carefully annotated volume, editors Zane McNeill, Riley Clare Valentine and Blu Buchanan take us from Jan. 1 (the date in 1962 when Illinois became the first state to repeal its “crimes against nature” statute) to Dec. 31 (when, in 1918, openly lesbian labor activist Marie Equi was convicted of sedition for criticizing corporate profiteering from the U.S. war effort).
McNeill, whose previous books include Y’all Means All and Deviant Hollers, answered questions about Be Gay, Do Crime by email.
This book required a massive data-gathering effort. What did you learn that surprised you? I was surprised by how much of gay history is difficult to organize and verify by specific dates. This makes sense though, because “gay history,” like much of history, is often represented by the wealthy and elite — those most likely to make it into the archive and have their history written down. We tried our best to include as much counter and radical queer history as possible, while still ensuring the information could be verified. Which of the book’s entries do you find especially fascinating or empowering? I hadn’t realized how much of the labor victories we usually credit to Franklin D. Roosevelt were in fact shaped by Eleanor Roosevelt and her circle of lesbian friends. This is just one example of many in the book that show how queer history has been eclipsed and, in many ways, rewritten from a cisgender and patriarchal perspective. By recovering and reexamining these histories, we gain a profoundly different understanding of the past — as well as a better understanding of our current political moment.

and our joy. Refusing to be silent and invisible greatly weakens them. That is why I ask y’all to read this book together in book clubs, bring it to your local outdoor library, and leave it at queer coffeeshops and LGBTQ centers.
Pride 4 at Columbus Pride in 2017, No Justice No Pride at D.C. Pride in 2017, and Black Lives Matter—Toronto organizers who halted Toronto Pride in 2016.
We sought to include as many of these groups, protests and conflicts as possible so that readers can learn from the past — both from tactics that proved successful and from those that fell short.
The stakes for LGBTQ people have always been high and are likely to remain so in the foreseeable future. How do folks hang onto joy? Joy itself is an act of resistance, demonstrating the resilience and ungovernability of queer and trans people despite state surveillance, criminalization and pathologization. Many entries in this book document the state’s attempts to crush queer and trans joy.
Police raids of William Dorsey Swann’s birthday drag ball in 1888, Eve’s Hangout in 1926, the Tay-Bush Inn in 1961, The Patch Bar in 1968, The Snake Pit in 1970, “Operation Soap” in 1981, the Glad Day Bookshop in 1982, Club Toronto’s Pussy Palace in 2000, and raids on gay leather bars in Seattle in 2024 show the state has long been threatened by queer and trans joy.

You urge readers not to read the book alone but to share it in community with others. Do you have particular suggestions for what that might look like? There is an increasing risk in being openly queer, reading queer books and creating queer spaces. But that is why it is so important to do just that. Learning from our history in community with others terrifies the far right. Fascists get power from making us small and scared — too scared to read, to dream, to live. But they are the ones who are so scared of us and our power
The LGBTQ community has long been targeted by the political right, but you also point to tensions or conflicts between different segments of the community. How can Be Gay, Do Crime help people better understand and navigate those conflicts? We try to highlight the many different visions of what liberation has meant. For example, the Mattachine Society began in the 1950s with a radical critique of mainstream society, but soon shifted toward a politics of respectability and acceptance within dominant culture. Frustration with these assimilationist tactics helped give rise to more radical groups such as the Gay Liberation Front and the Queens Liberation Front, which demanded broader structural change and greater inclusion of drag and trans communities. These tensions over tactics and goals — particularly over who is included in a group’s vision of liberation and who is left behind — have continued to surface within LGBTQ spaces. Queer activists have at times directly challenged other LGBTQ organizations, as seen with the Black
Yet despite such targeting, queer and trans people continue to carve out community and resist police violence. They protested each of these raids and the arrests that followed, showing up to confront the state in defense of their communities. This act of standing together is an expression of love. Every moment of protest documented in this book is also a moment of joy — because queer and trans people organizing, engaging in community defense, and fighting for liberation embody joy itself. To read an uncut version of this interview — and more local book coverage — please visit Chapter16.org, an online publication of Humanities Tennessee. ▼




Be Gay, Do Crime: Everyday Acts of Queer Resistance and Rebellion
Edited by Zane McNeill, Riley Clare Valentine and Blu Buchanan















An exhibition of art by Fahamu
BY JULIANNE AKERS

IDENTITY IS NOT always easy to define. On some days, we may think we know exactly who we are. But at other times, it requires removing masks we didn’t know were there to truly understand ourselves.
This idea is explored in an exhibition by Atlanta-based artist Fahamu Pecou at the Frist Art Museum. This Face Behind This Mask Behind This Skin displays paintings, sculptures and other mixed-media pieces, many of which come from Pecou’s series End of Safety, Real Negus Don’t Die and We Didn’t Realize We Were Seeds. Each piece works in conjunction with another to examine Black identity, masculinity and cultural and ancestral influences.
“What I’m attempting to express through the exhibition is a kind of removal of the kind of external influences and voices that shape our identity, so that we can really interrogate the internal one, and in that discover who we truly are,” Pecou tells the Scene
Pecou experiments with the idea of Afrotropes, a concept first named by art historians Huey Copeland and Krista Thompson to describe recurring visuals that have become symbols and icons within Black culture and history. This is seen as Pecou depicts objects like durags and cowrie shells throughout the
exhibit, attempting to reshape their traditional associations.
“Rather than just thinking about them as an aesthetic, I have been thinking about them as kind of like ritual objects, like this power invested in these symbols to have deep resonance and meaning,” Pecou says.
“I’m really sort of [invested] in transforming some of the ways we think about Black identity and Black culture, moving it away from a language of lack or trauma,” he adds.
The exhibition also features the debut of the artist’s short film “The Store,” a 13-and-a-halfminute Afro-surrealist picture that centers on a bodega. For sale inside the store are fictional Teacha-brand products, which transport users to a magical alternate reality. With monochrome and shimmering imagery, visitors of the store experience visions connecting them with Black ancestry and spiritual identity.
When visitors walk into the exhibit, they are immersed in the store — soda cans and cereal boxes adorned with the Teacha logo line shelves along the walls.
Three separate rooms make up the exhibit, filled with artwork that employs a wide range of artistic mediums that all come together to tell a larger story. One wall displays three transparent
backpacks sitting atop books. Inside the bags are resin sculptures, cotton and an Arizona Iced Tea can — all providing a glimpse inside our identities as defined by the objects we carry.
Another wall features Pecou’s 2014 painting Elevation of Fetish, which bounces off the wall via its vibrant yellow background. The piece draws on Air Jordan 1s as another example of an Afrotrope. Other acrylic pieces depict bright shades of blue, pink, purple and green, standing out among the Frist’s white walls and also providing a contrast among the exhibit’s recurring theme of positioning ourselves behind a mask.
Plastered along the wall just above one of these paintings is a James Baldwin quote: “Love takes off the masks we fear we cannot live without and know we cannot live within.”
At the center of another room is a large resin sculpture that depicts a person sitting down as they grasp a long, flowing veil covering their face. Visuals like these are apparent as you stroll through the exhibit, and come to reckon with the masks we all wear — and what it means to release ourselves from those veils of identity.
Pecou says while much of the work emphasizes experiences within Black culture, it also points toward humanity as a whole.
“I also assume a responsibility to define or
redefine that for myself — the right to not live in someone else’s idea of who I should be or what I can be,” Pecou says. “And I think that every single person on this planet, one form or another, asks themself that same question. It is a universalism that goes beyond skin color. It could be your spiritual identity, it could be your sexual identity. It could be your political identity. Whatever it may be, you at some point have to break with all of the ideas that you believed in order to determine and define for yourself who and what you are.”▼



























































HERE’S ONE WAY to counteract the music streaming landscape becoming increasingly dystopian: Build out a collection of physical media. This holiday season, treat the music fan in your life to some new vinyl! From the exclusive releases available during special shopping hours on Friday, Nov. 28, for Record Store Day Black Friday to quality vintage selections, Nashville’s panoply of independent record stores has you and your music-lovin’ loved ones covered. We’ll start our tour on the West Side at McKay’s (636 Old Hickory Blvd.), which does not participate in RSD Black Friday; they’ll be open regular hours Friday and Saturday. Alison’s Record Shop (994A Davidson Drive) will not have RSD exclusives but will be offering 15 percent off all weekend, with extended hours 10 a.m to 5 p.m. on Friday and Saturday. Phonoluxe (2609 Nolensville Pike) does not carry RSD exclusives but will stock new inventory of quality used vinyl for the big shopping weekend. Analog Your Life (2546 Lebanon Pike) will offer a limited selection of RSD exclusives, plus DJs, giveaways and a half-price sale on all used vinyl priced at $5 and under.
Third Man Records’ storefront (623 Seventh Ave. S.) carries only releases from their label, so they won’t have RSD exclusives. However, new treats are incoming: Limited quantities of The White Stripes’ The Complete Studio Albums Boxset — featuring all six records on 180-gram red-and-white vinyl plus previously unseen photos — will be available in person (while online orders won’t ship until next year). Karly Hartzman and MJ Lenderman Live at Third Man Records, recorded at The Blue Room in 2024, will also be available that day.
Hopping over the Cumberland, Grimey’s (1060 E. Trinity Lane) will have a wide variety of RSD exclusives, offered up in their typical menu-style format. Shoppers hoping to snag some of the new releases can queue up outside the store’s back door. They’ll open an hour early at 10 a.m. for the early birds and move the releases inside once the crowd has dissipated.
Elevator Vinyl (inside Lykke Haus, 490 E. Trinity Lane) won’t have any RSD exclusives or special
Your quick-reference guide to Record Store Day Black Friday 2025 in Nashville
BY HANNAH CRON


sales this time, but they plan to drop a recently acquired jazz collection including original pressings and rare titles. Check out the store’s Instagram account for a teaser video.
Daydream Records (1006 Fatherland St., No. 104A) specializes in used vinyl, so they don’t carry RSD releases. Hot on the heels of their one-year anniversary, they’ll have some special rare finds dropping throughout the day on Black Friday during their normal operating hours, 11 a.m. to 6 p.m.
Vinyl Tap (2038 Greenwood Ave.) will offer RSD exclusives and extensive sales on their regular inventory — in store and online — through Nov. 30. Used inventory as well as new CDs will be 15 percent off; signed records will be 25 percent off; specialty picture discs, 7-inch and 10-inch vinyl will be 30 percent off; and box sets will be 40 percent off. Cyber Monday (Dec. 1) will bring additional sales to the webstore, with 30 percent off restocks, signed records, 7-inch and 10-inch vinyl and picture discs; 40 percent off box sets; and 20 percent off everything else. As usual, there will be plenty of music to hear throughout the weekend, with WXNA DJs spinning Friday evening, karaoke Saturday night, and Stringjoy Presents: Noah Gunderson’s Cheap Date on Sunday.
Don’t see your favorite store listed? These events have tons of moving parts, and some stores didn’t get back to us in time to get details in print. Keep an eye on social media for up-


dated information from all your favorite spots, including The Groove, The Great Escape’s three area locations (the Charlotte Avenue flagship, the recently relocated Madison store and the Murfreesboro shop), Swaggie Records, Jimbo’s, and the newly reopened Ernest Tubb Record Shop
Among this Black Friday round of Record Store Day exclusives, there’s a thing or five for just about every kind of listener. We’re focusing on titles that will be for sale only in indie shops on Black Friday, but there are also plenty of RSDfirst releases that will be more widely available later. As always, the complete list of releases is available for your perusing pleasure on the Record Store Day website.
Why not pick up a new Christmas record to spin while you trim the tree? Options include Devo’s “Merry Something to You” 12-inch maxi-single picture disc, a 7-inch with Kesha’s cover of “Holiday Road” (including her 2010 YouTube rendition of “Have Yourself a Merry Little Christmas” on the B-side), or the classic Vince Guaraldi Trio soundtrack to A Charlie Brown Christmas in a special 60th anniversary pop-up gatefold package.
If you want to shop what’s capital-P Popular, check out backflipper Benson Boone’s Pulse EP, a 7-inch featuring Chappell Roan’s ’80s-inspired ballad “The Subway” backed with her countrified “The Giver,” and the eagerly awaited soundtrack to Wicked: For Good as a two-LP picture disc set. There are also Crosley turntables for


those on Santa’s Wicked list: one in Glinda pink and another in Elphaba emerald green.
Hip-hop offerings include the first vinyl release of GloRilla’s Ehhthang Ehhthang mixtape and a 20th anniversary edition of dynamic trio Little Brother’s The Minstrel Show. Fans of country and the country-adjacent have plenty of options, from Sierra Ferrell’s acclaimed Trail of Flowers on a picture disc and the special Last Call edition of Morgan Wade’s The Party Is Over to Jelly Roll’s deluxe Beautifully Broken (Pickin’ Up the Pieces) and Post Malone’s Long Bed, a collection of previously digital exclusive tracks from the deluxe version of F-1 Trillion
There’s a bevy of live albums on the list too, including titles from Cage the Elephant, Alice Cooper, Miles Davis, Elton John and Brandi Carlile, Briston Maroney and The Ramones (at CBGB!). There’s also The Original Freewheelin’ Bob Dylan (with songs cut from the landmark 1963 release restored to the track list) and Joni Mitchell’s Rolling Thunder Revue — we could go on. Go flip through some records, support an indie record store and find the perfect gift for someone you love. ▼
Watch your favorite stores’ social media for updates

East
Thomas Dolby remains a singular force in pop music
BY JASON SHAWHAN
BEYOND THE INESCAPABLE legacy of one of the most enduring and clever New Wave hits of the early 1980s — that’d be “She Blinded Me With Science” — what has always distinguished Thomas Dolby’s work is a playful appreciation for music in all of its forms, and a willingness to try new things and new sounds. A mad scientist of the synth lab and mixing board, he’s worked just as well with more rockist sensibilities, helping build bridges between all manner of subgenres and individuals. And that’s what makes him kind of a Zelig for the ’80s music scene as a whole, as well as one of the most fascinating people in the industry.
He was an essential part of the Mutt Lange process of helping rawk bands absorb new technologies and modes of recording, remaking and remodeling the very mindset that shaped how music was made at the time. He’s all over Foreigner’s 4 and Def Leppard’s Pyromania, made right as those bands were ramping up to whole new levels in what their sounds would become. And at the same time, he was also producing Whodini’s “Magic’s Wand” — so he’s also working the early stages of commercial hip-hop out of sheer love for the game, same as he would do for the sophisti-pop apotheosis of Prefab Spout later in the decade.
Before he put out his own first single, he wrote Lene Lovich’s hit “New Toy,” immortal to poptimists and holiday shoppers alike, setting himself up as a collaborator with fascinating women in music. Another notable example is Contortions keyboardist Adele Bertei’s first single “Build Me a Bridge,” a remarkable Rosetta Stone of a New York club record that feels right in freestyle, Ital-

odisco, breakdance and Hi-NRG DJ sets despite defiantly doing its own thing. Yet another is late Yemenite singer Ofra Haza’s throbbing 1989 tashthouse single “Taw Shi,” which still sounds futuristic and ancient at the same time, a singular object built to make asses quake.
Dolby’s film score work is innovative, sometimes challenging. His score for the 1986 Ken Russell film Gothic is a marvel of anachronism and syncopated menace, and the songs and compositions he did for the infamous Howard the Duck serve the material perfectly — a perfect synecdoche of the mid-’80s that modern nostalgia skins never dig deep enough for. If you’ve never seen the 1990 Luca Bercovici film Rockula — and you should, because it rules — you’ll miss Dolby’s acting debut as a coffin impresario/Van Helsing wannabe who swordfights an angsty vampire who’s started a band that features Bo Diddley and Susan Tyrell. It is a delightful performance in a delightful film that indicates how much fun the world of music and media is around Thomas Dolby.
The tradition of the answer record is long and, while not noble, an essential part of mass culture. And after some criticism of his 1988 club jam “Airhead,” he worked with a female MC and recorded the answer record to his own single, doing the work to address and learn from his own drama. This is someone you just have to respect.
Remember that period of time in the Aughts when we loved to get calls on our phones? So much so that we would get polyphonic ringtones of our favorite jams and deploy them like little bite-size fragments of joy to spice up the day? Dolby helped develop the company and technology whereby that happened.
I can’t be objective, and I can’t get into the harmonics and the modalities and the full history of why. But Thomas Dolby is one of the coolest people alive, and he’s coming to the Beast on Sunday to remind us all that music is not only a liberating form of collective evolution, but also crazy fun. ▼
Saturday, November 29
SONGWRITER SESSION Sandy Knox NOON · FORD THEATER
Sunday, November 30
GLOBAL ADVOCACY DAY Museum Store Sunday
ALL DAY · THE MUSEUM STORE
Sunday, November 30
HOLIDAY POP-UP
Ornaments at Hatch Show Print
10:00 am · HATCH SHOW PRINT SHOP
Sunday, November 30
MUSICIAN SPOTLIGHT Adam Shoenfeld 1:00 pm · FORD THEATER
Saturday, December 6
HOLIDAY RETAIL POP-UP Dolly Parton x Kendra Scott
10:00 am · THE MUSEUM STORE
Saturday, December 6
SONGWRITER SESSION HARDY
NOON · CMA THEATER
Saturday, December 6
HATCH SHOW PRINT Block Party
3:00 pm · HATCH SHOW PRINT SHOP
Sunday, December 7
HATCH SHOW PRINT Family Block Party
9:30 am · HATCH SHOW PRINT SHOP
WITNESS HISTORY
Local Kids Always Visit Free Plan a trip to the Museum! Local youth 18 and under who are residents of Nashville-Davidson and bordering counties always visit free, plus 25% off admission for up to two accompanying adults.
Become



Career-best performances from Jessie Buckley and Paul Mescal elevate Chloe Zhao’s Hamnet
BY D. PATRICK RODGERS

NOT MUCH IS known about the personal lives of William Shakespeare, his wife or their three children, only two of whom survived to adulthood. Cinema is littered with various filmmakers’ attempts to fill in the gaps in Shakespeare’s biography with speculation or outright fiction, from successful Oscar bait (1998’s Best Picture-winning Shakespeare in Love) to more forgettable offerings (2018’s Kenneth Branagh-directed All Is True).
The latest entry in the canon of liberty-taking Shakespearean biopics is Hamnet, adapted from Maggie O’Farrell’s award-winning 2020 novel of the same name. With a script co-written by O’Farrell and Chloé Zhao, Hamnet — also directed by Zhao, back from Marvel land after 2021’s largely panned MCU entry Eternals — tells the story of Shakespeare’s domestic life, mostly through the eyes of his wife, and the grief the couple shares after the loss of a child.

often oppress or underestimate them, and they quickly begin a torrid romance. The brooding and impossibly good-looking Will tells Agnes he has “no talent for waiting,” and soon enough, Agnes is pregnant and the couple is wed.
depressed one — who loves his family but longs for the artistic opportunities afforded by London. And then, death visits his young family.
The Bard’s partner is referred to as both Anne and Agnes in historical texts, and here she’s Agnes, played by wildly underappreciated Irish actress Jessie Buckley (The Lost Daughter, Men, Women Talking). Agnes is rumored to be the daughter of a witch of the woods, and she herself is mysterious, beautiful and aloof, with an almost supernatural connection to life’s great mysteries. Wandering the forest, creating poultices and training her beloved falcon, Agnes attracts the attention of local tutor Will Shakespeare (Paul Mescal) — a “pasty-faced scholar,” as her brother refers to him. Both Will and Agnes are from troubled homes, with spirits and personalities too big for the families who
It’s to Zhao’s credit that the film doesn’t much concern itself with hyperrealistic portrayals or period-correct dialogue. The costuming and the sets are certainly as convincing as they need to be — Mescal isn’t wearing an Apple Watch or anything, though he does sport that same hairstyle his characters pretty much always have. No wig and prosthetic nose, à la Branagh’s All Is True. But Hamnet is far more convincing in its emotional commitment than its historical commitment. It’s a film about the hardships of mere existence and the restorative power of domestic life, and it just so happens that the patriarch of this budding family will ultimately become the most famous writer in the history of the written word.
Destiny, of course, eventually comes calling for Will, a tortured artist — possibly a clinically
“Mourning Parent” is a role that always gives actors plenty to sink their teeth into, but Buckley’s portrayal of the griefstricken Agnes is among the most breathtaking performances in film this year. Even in wide shots her presence fills the screen, and in closeups she’s transfixing. In Hamnet’s gut-wrenching final moments, Buckley’s face becomes the emotional fulcrum of the entire film. And it’s a face capable of displaying so much emotion — coy, smirking playfulness; bitter rage; agony. So much agony. Hamnet is no period-piece romp. It isn’t even so much about the historical what-ifs that Zhao and O’Farrell’s script poses and attempts to answer. Really, it’s a simple but affecting character study, thoughtfully rendered but elevated to year’s-best status by devastating performances from its two leads. And the rest? Well. The rest is silence. ▼
Hamnet PG-13, 125 minutes
Now playing at the Belcourt and AMC Thoroughbred 20

42 Composers’ rights org.
1 Areas of development
6 Punch-in-the-stomach sounds
10 Genre for Blackpink and Stray Kids
14 Helvetica-like typeface
15 Button to hit after accidentally deleting an entire manuscript
16 International footwear retailer based in Quebec
17 Stealthiest of stealthy warriors
19 Warren Beatty film based on “Ten Days That Shook the World”
20 Reporters often carry them
21 Relaxed
23 “Call Her Daddy” podcast host Cooper
24 Words of denial
26 “___ Just Not That Into You”
27 Activist Brockovich
29 Case opener
33 Location that requires tickets for checking out, but not checking in
36 End of a municipal address?
37 1887 drama on which a Puccini opera is based
40 Things opened before passengers exit an aircraft
43 Difference between a B and a C, perhaps
45 Star of NBC’s “The Blacklist”
47 TV’s warrior princess
50 “Done!,” in geometry class
51 Brief moments, in brief
54 ___ Hashana
56 Units equal to roughly a quarter of a calorie
59 Cook outside?
61 River through Kazakhstan
62 Sports craze of the 2020s … as seen three times in this grid?
64 Little more than
65 Ingredient in some mouthwashes
66 Clay being of Jewish folklore
67 Troubadour, e.g.
68 Thomas Hardy heroine who’s described as “a pure woman”
69 Wheel connectors DOWN
1 “Should we?,” informally
2 A.L. East athlete
3 Money maker
4 Peninsula south of California, colloquially
5 It’s an affront
ANSWER TO PREVIOUS PUZZLE
A
than 9,000 past puzzles, nytimes.com/crosswords ($39.95 a year). Read about and comment on each puzzle: nytimes.com/ wordplay. Crosswords for young solvers: nytimes.com/ studentcrosswords.
6 One-up
7 Worst-possible Amazon rating
8 Prez on a U.S. coin
9 Slugger Sammy
10 Holder of the N.B.A.’s career points record before LeBron passed him in 2023
11 “You’ve overstayed your welcome”
12 Figures on DraftKings or FanDuel
13 Put forward
18 ___ Nicolas, remotest of California’s Channel Islands
22 Set of notches in a dictionary
25 Classic Camaros
28 “Didn’t mean to offend you”
30 Best ever, informally
31 Neither’s partner
32 Common fixtures over fireplaces
34 Part of U.S.M.A.: Abbr.
35 Accounts
37 Prez two decades after 8-Down
38 “I’ll answer all your questions” session, online
39 Site of a huge annual crowd
41 High place to view a high art
44 Paintings on plaster
46 Bit of food for a hamster
48 Some
49 ___ Simpson, musical sister of Jessica
52 Certain salad veggies
53 Where Rudolph could first be seen in 2000, for short
55 Command posts
56 Checkers move
57 Product with a Cakesters variety
58 Said angrily
60 Lou ___, “Mambo No. 5” singer
63 Speck in la Seine




FORECLOSURE SALE NOTICE
WHEREAS, Timothy Brian Malone and Lakesha Baldwin Malone, exe-cuted a Tennessee Deed of Trust, Security Agreement and Assign-ment of Rents and Leases dated February 26, 2025, of record at In-strument No. 202503250022243, Register’s Office for Davidson County, Tennessee, (the “Deed of Trust”) and conveyed to Michael Anthony Shaw, as Trustee, the hereinafter described real property to secure the payment of certain in-debtedness (“Indebtedness”) owed to Edgefield Holdings, LLC, a Dela-ware limited liability company ( “Lender”); and WHEREAS, default in payment of the Indebtedness secured by the Deed of Trust has occurred; and WHEREAS, David M. Anthony (“Trustee”) has been appointed Substitute Trustee by Lender by that Appointment of Substitute Trustee of record at Instrument 202510200083416, Register’s Of-fice for Davidson County, Tennes-see, with authority to act alone or by a designated agent with the powers given the Trustee in the Deed of Trust and by applicable law; and WHEREAS, Lender, the owner and holder of said Indebtedness, has demanded that the real property be advertised and sold in satisfaction of said Indebtedness and the costs of the foreclosure, in accordance with the terms and provisions of the loan documents and Deed of Trust.
NOW, THEREFORE, notice is hereby given that the Trustee, pur-suant to the power, duty and author-ity vested in and imposed upon the Trustee under the Deed of Trust and applicable law, will on Friday, December 19, 2025, at 1:00 o’clock p.m., prevailing Nashville time, on the steps of the historic Davidson County Courthouse, 1 Public Square, Nashville, Tennessee 37201, offer for sale to the highest and best bidder for cash and free from all rights and equity of redemp-tion, statutory right of redemption or otherwise, homestead, dower, elec-tive share and all other rights and exemptions of every kind as waived in said Deed of Trust, certain real property situated in Davidson County, Tennessee, described as follows: Legal Description: The real property is described in the Deed of Trust at Instrument 20250325-0022243, Register’s Office for Davidson County, Tennessee.
The Land referred to herein below is situated in the County of Davidson, State of Tennessee, and is de-scribed as follows: Land in Davidson County, Tennes-see, being Lot No. 22 on the plan of WEAKLEY AND DODD’S SUBDI-VISION OF LOT NO. 17
IN BROOKLYN, as shown by plat of record in
Plat Book 57, page 126, in the Register’s Office for Davidson County, Tennessee, to which plat reference is hereby made for a more complete description.
Said Lot No. 22 fronts 50 feet on the southerly side of Highview Avenue and runs back 1481/3 feet on the easterly line and 150 feet on the westerly line with the easterly mar-gin of Weakley Avenue to an alley, measuring 50 feet, more or less, thereon.
This being the same property con-veyed from a parcel of land con-veyed to TLM
HOLDING LLC by Quitclaim Deed from LAKESHA BALDWIN MALONE and TIMOTHY BRIAN MALONE. The said Quit-claim Deed is of record as Instru-ment No. 202201250009091 in the Register’s Office of Davidson County, Tennessee, to which a ref-erence is here had.
Being the same property conveyed to
Lakesha Baldwin Malone and Timothy Baldwin Malone by Quit-claim Deed of record at Instrument No. 20221018-0113498, Davidson County Register of Deeds Office.
Map/Parcel No: 071-14-0-090.00
Street Address: The street address of the property is believed to be 132 Fern Avenue, Nashville, Tennessee 37207, but such address is not part of the legal description of the property. In the event of any discrep-ancy, the legal description herein shall control.
Other interested parties: Rocket Mortgage, LLC dba Quicken Loans Inc.; Freedom Mortgage Corpora-tion; Pinnacle Bank; Dooley Brad-ley; Regions Bank. THIS PROPERTY IS SOLD AS IS, WHERE IS AND WITH ALL FAULTS AND WITHOUT ANY REPRESENTATIONS OR WAR-RANTIES OF ANY KIND WHAT-SOEVER, WHETHER EXPRESSED OR IMPLIED, AND SUBJECT TO ANY PRIOR LIENS OR ENCUMBRANCES, IF ANY. WITHOUT LIMITING THE GENER-ALITY OF THE FOREGOING, THE PROPERTY IS SOLD WITHOUT ANY REPRESENTATIONS OR WARRANTIES, EXPRESSED OR IMPLIED, RELATING TO TITLE, MARKETABILITY OF TITLE, POS-SESSION, QUIET ENJOINMENT OR THE LIKE AND WITHOUT ANY EXPRESSED OR IMPLIED WAR-RANTIES OF MERCHANTABILITY, CONDITION, QUALITY OR FITNESS FOR A
GENERAL OR PARTICULAR USE OR PURPOSE.
As to all or any part of the Property, the right is reserved to (i) delay, continue or adjourn the sale to an-other time certain or to another day and time certain, without further publication and in accordance with law, upon announcement of said delay, continuance or adjournment on the day and time and place of sale set forth above or any subse-quent delayed, continued or ad-journed day and time and place of sale; (ii) sell at the time fixed by this Notice or the date and time of the last delay, continuance or adjourn-ment or to give new notice of sale; (iii) sell in
such lots, parcels, seg-ments, or separate estates as Trus-tee may choose; (iv) sell any part and delay, continue, adjourn, can-cel, or postpone the sale of any part of the Property; (v) sell in whole and then sell in parts and consummate the sale in whichever manner pro-duces the highest sale price; (vi) and/or to sell to the next highest bid-der in the event any high bidder does not comply with the terms of the sale. Substitute Trustee will make no covenant of seisin, marketability of title or warranty of title, express or implied, and will sell and convey the subject real property by Trustee’s Quitclaim Deed as Substitute Trus-tee only. This sale is subject to all matters shown on any applicable recorded Plat or Plan; any unpaid taxes and assessments (plus penalties, inter-est, and costs) which exist as a lien against said property; any restrictive covenants, easements or set-back lines that may be applicable; any rights of redemption, equity, statutory or otherwise, not other-wise waived in the Deed of Trust, in-cluding rights of redemption of any governmental agency, state or fed-eral; and any and all prior deeds of trust, liens, dues, assessments, en-cumbrances, defects, adverse claims and other matters that may take priority over the Deed of Trust upon which this foreclosure sale is conducted or are not extinguished by this Foreclosure Sale. This sale is also subject to any matter that an inspection and accurate survey of the property might disclose.
As of July 1, 2025, notices pursuant to Tennessee Code Annotated § 35-5-101 et seq. are posted online at https:// foreclosuretennes-see.com by a third-party internet posting company.
THIS 26th day of November, 2025. David M. Anthony, Substitute Trus-tee EXO LEGAL PLLC
P.O. Box 121616 Nashville, TN 37212 david@exolegal.com - 615-869-0634
NSC 11/27, 12/4, 12/11/25
FORECLOSURE SALE NO-TICE WHEREAS,
Timothy Brian Malone executed a Tennessee Deed of Trust, Security Agreement and As-signment of Rents and Leases dated February 26, 2025, of record at Instrument No. 20250325-0022338, Register’s Office for Da-vidson County, Tennessee, (the “Deed of Trust”) and conveyed to Michael Anthony Shaw, as Trustee, the herein-after described real property to secure the payment of certain indebtedness (“Indebted-ness”) owed to Edgefield Holdings, LLC, a Delaware limited liability company “Lender”); and WHEREAS, default in payment of the In-



debtedness secured by the Deed of Trust has occurred; and WHEREAS, David M. Anthony (“Trustee”) has been appointed Substitute Trustee by Lender by that Appoint-ment of Substitute Trustee of record at Instrument 20251020-0083417, Regis-ter’s Office for Davidson County, Tennessee, with au-thority to act alone or by a designated agent with the powers given the Trustee in the Deed of Trust and by ap-plicable law; and WHEREAS, Lender, the owner and holder of said Indebtedness, has de-manded that the real property be advertised and sold in satisfaction of said Indebted-ness and the costs of the foreclosure, in accordance with the terms and provisions of the loan documents and Deed of Trust. NOW, THEREFORE, notice is hereby given that the Trus-tee, pursuant to the power, duty and authority vested in and imposed upon the Trus-tee under the Deed of Trust and applicable law, will on Friday, December 19, 2025, at 1:15 o’clock p.m., prevail-ing Nashville time, on the steps of the historic Davidson County Courthouse, 1 Public Square, Nashville, Tennes-see 37201, offer for sale to the highest and best bidder for cash and free from all rights and equity of redemp-tion, statutory right of re-demption or otherwise, homestead, dower, elective share and all other rights and exemptions of every kind as waived in said Deed of Trust, certain real property situated in Davidson County, Tennes-see, described as follows: Legal Description: The real property is described in the Deed of Trust at Instrument 20250325-0022338, Regis-ter’s Office for Davidson County, Tennessee. The Land referred to herein below is situated in the County of Davidson, State of Tennessee, and is described as follows: Being in the 13th formerly the 23rd, Civil District of said County and State, being part of Lot No. 11 on the plan of the partition of the Elias Simpkins Estate, as of record in plan book 2, page 65, Chancery Court at Nashville for said County and a 2.53 acre tract of land lying east of and adjacent to said Lot No. 11 described together as fol-lows: Beginning at a point on the easterly margin of the Hydes Ferry Pike or State Highway No. 12, 5.8 feet northerly from the southwest corner of a part of Lot No. 11 conveyed to Estelle E. Bess by Henry Jones and wife, by deed of record in Book 1295, page 294, Register’s Office for said County; thence north 42 deg. 45’ east 143.4 feet to an iron pin; thence north 38 deg. 45’ west 151.6 feet to an iron pin; thence south 42 deg. 45’ west 19.5 feet to an iron pin, the southeast corner of a part of Lot No. 11 conveyed to Lewis J. Daniels and wife, by John G. Glaus and wife, by deed of record in Book __, Page __, said Register’s Of-fice; thence with the eastern boundary line of said Daniels’ property, north 39 deg. 45’ west 103 feet to an iron pin, the southeast corner of the property conveyed to C.D. Taylor and wife, by Andy J. Glaus and wife, by deed of record
ENJOY THE OUTDOORS
Cheekwood
Nashville Zoo
OUTING
Adventure Science Center
in Book 2045, Page 523, said Register’s Office; thence with the eastern boundary line of said Taylor property north 36 deg. 30’ west 138 feet to an old iron pin, the southeast corner of the property conveyed to Oli-ver W. Davenport and wife, by Gilbert E. Martin and wife, by deed of record in Book 2019, Page 25, said Regis-ter’s
bidder in the event any high bidder does not comply with the terms of the sale. Substitute Trustee will make no covenant of sei-sin, marketability of title or warranty of title, express or implied, and will sell
OR WAR-RANTIES OF ANY KIND WHATSOEVER, WHETHER EXPRESSED OR IMPLIED, AND SUBJECT TO ANY PRIOR LIENS OR ENCUM-BRANCES, IF ANY. WITH-OUT LIMITING THE GEN-ERALITY OF THE FOREGOING, THE PROPERTY IS SOLD WITHOUT ANY REP-RESENTATIONS OR WAR-RANTIES, EXPRESSED OR IMPLIED, RELATING TO TI-TLE, MARKETABILITY OF TITLE, POSSESSION, QUIET ENJOINMENT OR THE LIKE AND WITHOUT ANY EXPRESSED OR IM-PLIED WARRANTIES OF MERCHANTABILITY, CON-DITION, QUALITY OR FIT-NESS FOR A GENERAL OR PARTICULAR USE OR PURPOSE. As to all or any part of the Property, the right is reserved to (i) delay, con-tinue or adjourn the sale to another time certain or to an-other day and time certain, without further publication and in accordance with law, upon announcement of said delay, continuance or ad-journment on the day and time and place of sale set forth above or any subse-quent delayed, continued or adjourned day and time and place of sale; (ii) sell at the time fixed by this Notice or the date and time of the last delay, continuance or ad-journment or to give new no-tice of sale; (iii) sell in such lots, parcels, segments, or separate estates as Trustee may choose; (iv) sell any part and delay, continue, adjourn, cancel, or postpone the sale of any part of the Property; (v) sell in whole and then sell in parts and consummate the sale in whichever manner produces the highest sale price; (vi) and/or to sell to the next highest
Radnor Lake State Park















































